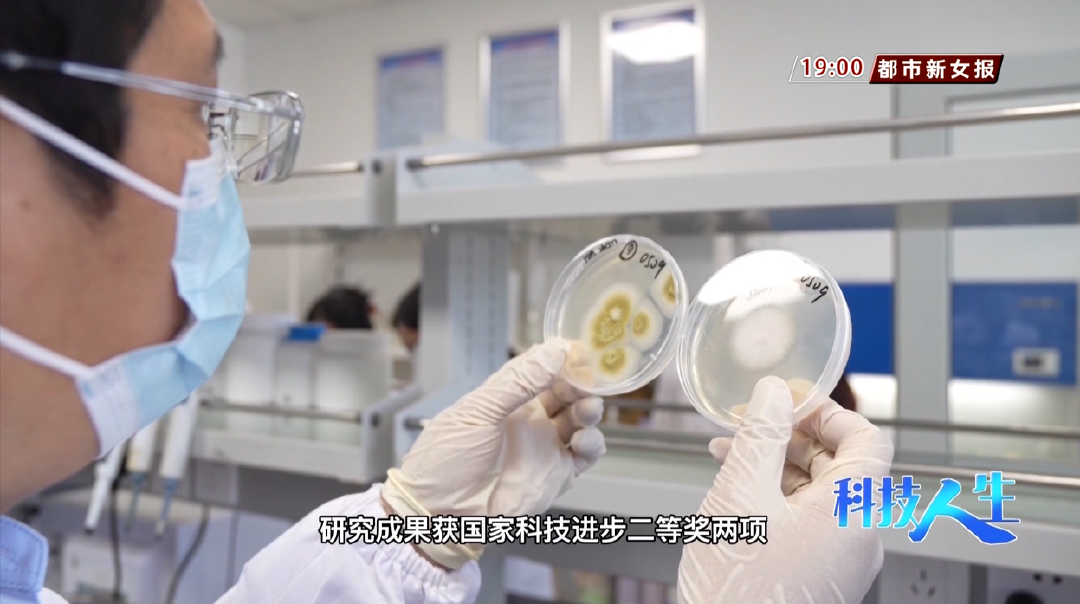
5.png

问题分诊室
【济南都市频道】“创新型创业者”彭立增,二十载追新路只为制药梦
发布时间: 2025-03-10

科学家精神是中国共产党人精神谱系的重要组成部分。弘扬科学家精神,不仅能激发科技工作者的创新热情,同时也激励着更多的科技工作者勇担重任,为国家的科技发展和进步贡献力量。
“科技人生”——济南市优秀科技工作者系列宣传工程,将展播济南市优秀科技工作者的事迹,了解他们在科学探索之路上的故事,感受科学家精神的无限魅力。
今天,我们展播的是《“创新型创业者”彭立增,二十载追新路只为制药梦》。
“创新型创业者”彭立增
2018年,电影《我不是药神》火爆荧屏。伴随影片引发热议的,还有原研药和仿制药的巨大差价。什么是原研药,什么又是仿制药呢?顾名思义,原研药就是原创性的新药,仿制药就是在原研药的专利保护期过期后,进行仿制的药品。
原研药和仿制药在效果基本没有差别,但价格差距很大。相较于原研药,仿制药的成本能降低70%~80%。

可以说,仿制药给需要这种药品的老百姓极大地降低了看病吃药的成本。我们今天要认识的这位优秀科技工作者,为了让老百姓能吃上便宜的好药,在制药行业深耕了二十年,从仿制药到创新药,可以说是他毕生奋斗的目标。
疗效与原研药相同,但价格却只有它的几分之一。合格的仿制药,解决了老百姓吃不起药的大难题,而这正是包括彭立增在内,中国几代制药人努力的目标。

2003年,博士毕业的彭立增来到鲁南制药,带领团队仅用六年时间就攻克了瑞舒伐他汀、法罗培南钠、米力农等仿制药的重大技术难题,让老百姓吃上了便宜药、放心药。

彭立增说,“我们不能老是做这种仿制药,我们最终还是要走从仿制到创新的这样一个过程。我们一直围绕着创新药这个梦想在努力,在奋斗,从来没有放弃。我想,困难的话他是有时间的,如果我们用长时间来布局解决一个困难,我觉得很多困难是能够克服的。”
从仿制到创新,为了实现心中的制药梦,彭立增的脚步从未停下。投身制药行业二十一年来,他先后主持了十多个新药项目的研究开发,完成了2项国家级项目、13项省市级项目,获得新药生产批件8项,其中6项成果在国内实现首家或独家上市,研究成果获国家科技进步二等奖2项,中国专利优秀奖2项,山东省科学技术进步奖一等奖、三等奖各1项。

他创办的爱思医药科技有限公司已实现销售收入累计7亿元,被认定为国家高新技术企业,工信部工业企业知识产权运用试点企业,获得山东省瞪羚企业荣誉称号。
“我对自己的定位就是创新型的创业者,有自己创业平台的创新人员科技人员。”彭立增如是说。

作为国家“万人计划”领军人才、科技部创新人才、推进计划科技创新创业人才,彭立增一直致力于让科技真正服务于产业,让研制创新药的梦想照进现实。

济南都市频道
Copyright © 2022 中国科学技术协会 版权所有 | 京ICP备16016202号-20